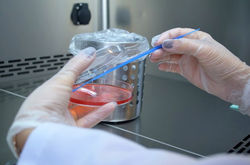

OUR ACTIVITIES
-
Product trials and analysis
-
Increasing performance, improving product quality
-
Product development
-
R&D activities
Laboratory analysis
-
Microscopic examination (oocyst count)
-
Salmonella analysis (ISO6579-1)
-
Microbiological examination
-
Antibiotic susceptibility test (6 discs)
-
qRT-PCR analysis
-
Serological examination (ELISA)
-
Vaccine Control (Salmonella)
-
Mycological analysis and typing
-
Microbiological Analysis in Pet Animals
-
Education

OUR ACTIVITIES
-
Problem analysis and solution in business
-
Product trials and analysis
-
Increasing performance, improving product quality
-
Product development
-
R&D activities
Laboratory analysis
-
Microscopic examination (oocyst count)
-
Salmonella analysis (ISO6579-1)
-
Microbiological examination
-
Antibiotic susceptibility test (6 discs)
-
qRT-PCR analysis
-
Serological examination (ELISA)
-
Vaccine Control (Salmonella)
-
Mycological Analysis and Typing
-
Microbiological Analysis in Pet Animals
-
Education


OUR LABORATORY
-Scientific research and product development studies
-Analyzes made in our laboratory with veterinary diagnosis and analysis license
-Diagnosis of poultry diseases
-Diagnosis of farm animal diseases
-Diagnosis of fish diseases
LABORATORY UNITS
-
Microbiology 1-2
-
Isolation and identification
-
Typing
-
Antibiotic susceptibility test
-
Serology
-
ELISA
-
Molecular biology and molecular typing (qRT-PCR)
-
molecular diagnosis
-
Molecular typing
OUR QUALITY POLICY
-
To perform test services on the basis of confidentiality with our equipped personnel and devices,
-
To provide services in accordance with all National and International standards, laws and regulations that we are responsible for, primarily the ISO 17025 standard,
-
Aiming the continuous improvement of our Service Quality by effectively applying the ISO 17025 standard,
-
To comply with the quality system documentation, policies and procedures with all our employees, including the management and all laboratory staff involved in the test studies,
-
To act in accordance with the ISO 17025 standard as the management of the laboratory establishment and to continuously improve the effectiveness of its management.
-
To ensure the continuation of impartiality in all experimental activities carried out by our laboratory,
-
Our laboratory is to continue its experimental activities with competent management and personnel.


OUR PROJECTS
Cattle
"Development of health control programs in farm animals"
Poultry
"Health control program for poultry enterprises"

GALLERY
![]() | ![]() | ![]() |
|---|---|---|
![]() | ![]() | ![]() |
![]() | ![]() | ![]() |
![]() | ![]() |
How should I send samples?
How do I create an analysis request?
Cold chain (2-8 °C) conditions must be provided for samples to be sent to our laboratory. If necessary, you can contact us before the sample is sent.
You can create your analysis requests by selecting them by animal type from the analysis request section on our website.
Analyzes made in our laboratory can be found on our website.our analysis list You can access it from the section.
What analyzes are performed in the laboratory?
How can I access the analysis results?
Which species are used in the laboratory?
Is analysis being done?
In our laboratory, analyzes are carried out for the diagnosis and problem solving of poultry, pet animals, fish, ruminant and horse diseases.
You can access your analysis results with the username and password defined by you in the "my analysis results" section on our website. Additionally, your analysis results are sent to the e-mail addresses you share with us.